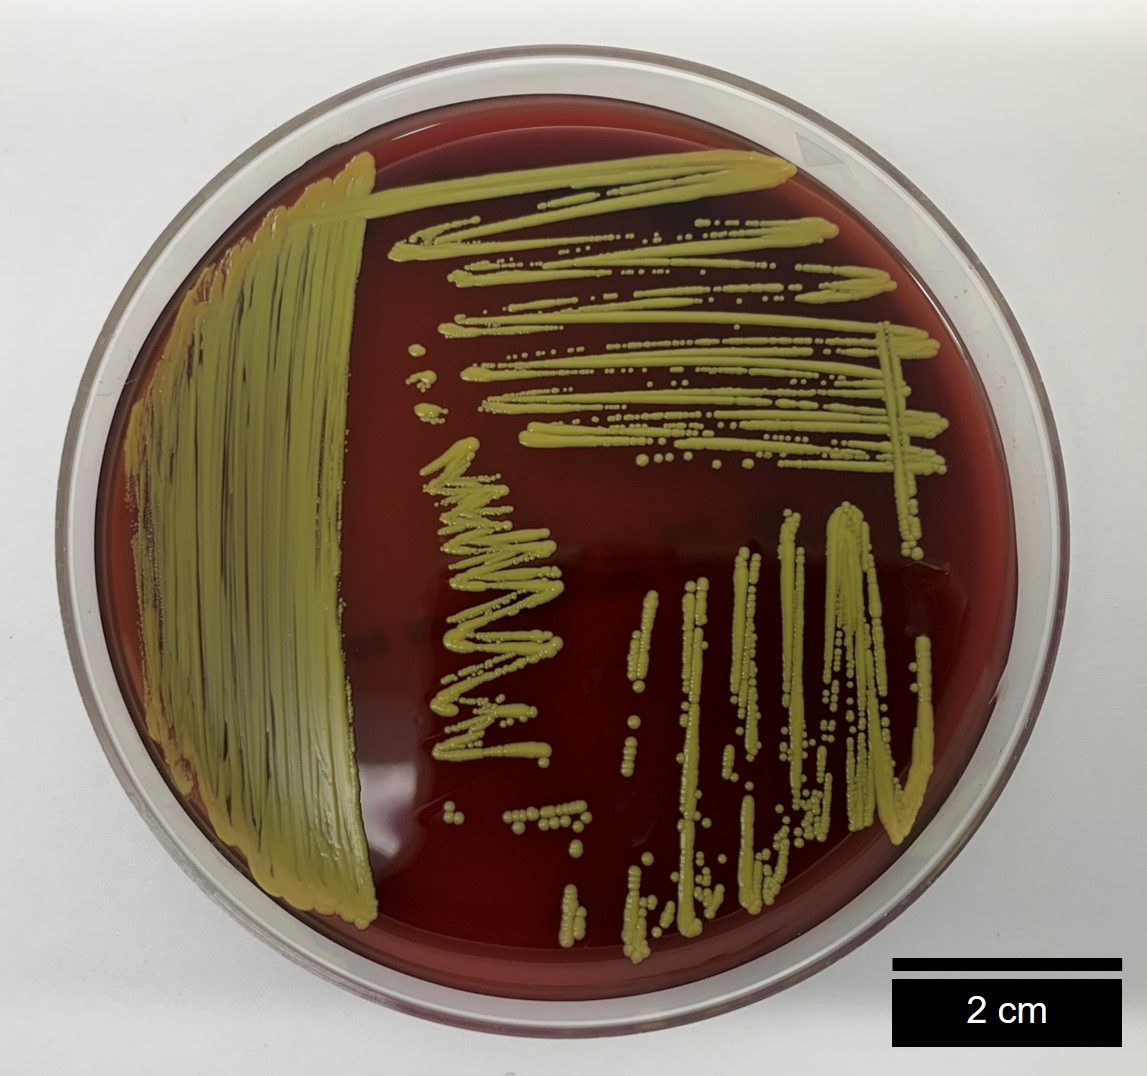
Darwin Core

Buscando facilitar el registro y la publicación de datos microbiológicos, la Colección de Microorganismos de la Pontificia Universidad Javeriana (CMPUJ) junto al SiB Colombia, desarrollaron una plantilla temática que contiene los principales elementos del estándar Darwin Core y extensiones asociadas a microorganismos, para que los investigadores puedan ingresar sus datos microbiológicos y se pueda visibilizar la biodiversidad microbiana en Colombia.
Encuentra aquí la nueva versión de la plantilla temática
Principales características de la plantilla de datos microbiológicos
Las principales características de esta nueva plantilla temática son la sugerencia de términos específicos para el registro y publicación de datos de microorganismos, que permitirán que se documente la información con una mayor precisión y consistencia.
Para conocer más sobre estos beneficios, en el archivo Excel encontrarán una hoja de instrucciones donde se explica en qué casos usar esta plantilla y cómo documentar cada elemento. Adicionalmente, se incluyó ejemplos particulares asociados a los datos de microorganismos, que ayudan a identificar en qué elementos se debe documentar cierta información y la forma correcta de hacerlo. La plantilla también incorpora algunos elementos provenientes de distintas extensiones que resultan relevantes para este tipo de datos, como método de preservación, préstamo de especímenes y tipo de permiso utilizado.